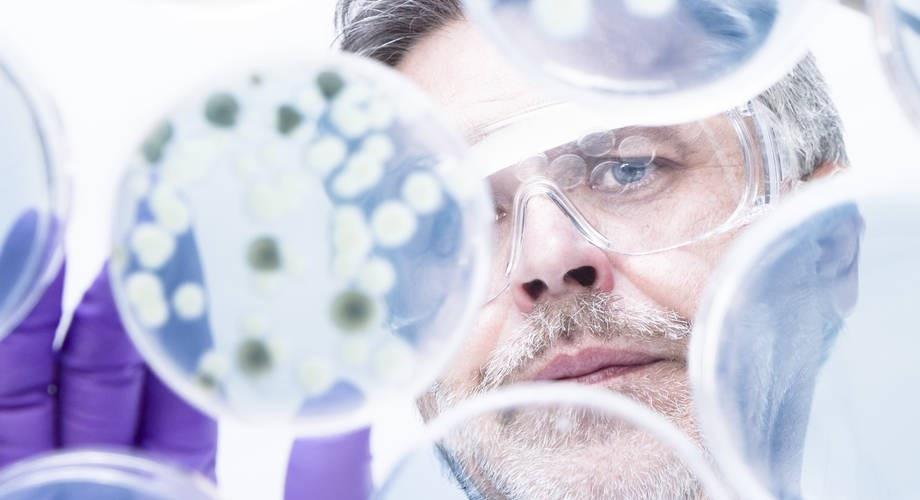
Mies katsoo suojalasit päässä labramaljaa.

Mikrobilääkkeiden herkkyyden tulkinnassa käytettäviin SIR-määritelmiin tulossa muutoksia
Suomessa käytetään Eurooppalaisen mikrobilääkkeiden herkkyysmäärityskomitea EUCASTin suosittelemia herkkyysmääritysmenetelmiä ja tulkintataulukoita mikrobilääkeresistenssin määrittämiseen. EUCAST on muuttanut mikrobilääkkeiden herkkyystulkintojen (SIR) määritelmiä. Uudet määritelmät otetaan käyttöön asteittain vuoden 2020 aikana.
Uuden määritelmän mukaan I-luokkaan kuuluvia lääkkeitä voidaan käyttää potilaan hoitoon silloin, kun käytetään isoa lääkeannostusta. Muiden tulkintojen määritelmät ovat pysyneet käytännössä ennallaan, eli R tarkoittaa resistenttiä ja S herkkää mikrobia.
”Muutoksen jälkeen S-tulkinnat tulevat vaihtumaan I:ksi tietyillä bakteeri-lääkeyhdistelmillä. Tämä johtaa muutoksiin joidenkin tuttujen, paljon käytettyjen lääkkeiden kohdalla ja edellyttää tiedottamista ja kouluttamista ennen kuin uuden määritelmän mukaiset tulkinnat otetaan kattavasti käyttöön”, toteaa Turun yliopistollisen keskussairaalan ylilääkäri ja Suomalaisen mikrobilääkeresistenssin tutkimusryhmän, FiRen puheenjohtaja Antti Hakanen.
Uudistuksen tarkoituksena on parantaa herkkyysmääritysten ohjaavaa vaikutusta mikrobilääkkeen ja sen annostuksen valinnassa. Lisäksi sen avulla halutaan vähentää laajakirjoisten mikrobilääkkeiden käyttöä.
Uusille määritelmille perustuvat tulkintarajat ja lääkkeiden annostelukäytännöt löytyvät uusimmasta EUCAST:n taulukosta (versio 10.0).
EUCAST:n uudet SIR-määritelmät tarkennuksineen
- S – Herkkä, standardi annostus: Terapeuttinen hoitovaste on todennäköinen lääkkeen standardiannostuksella.
- I – Herkkä, iso annostus: Terapeuttinen hoitovaste on todennäköinen, mikäli lääkkeen pitoisuutta infektiofokuksessa voidaan nostaa.
- R – Resistentti, suuri todennäköisyys, että hoito mikrobilääkkeellä epäonnistuu.
Lisätietoja
EUCAST:n uudet SIR-määritelmät
EUCAST
Video uusien määritelmien perusteluista (22:50)
EUCAST
EUCAST:n ohje uusien määritelmien soveltamisesta käytäntöön (pdf)
EUCAST
Annostukset-taulukko, johon SIR-tulkinnat perustuvat
EUCAST
Kaisu Rantakokko-Jalava
Osastonylilääkäri
Turun yliopistollinen keskussairaala
p. 02 313 3946
[email protected]
Antti Hakanen
Ylilääkäri,
Turun yliopistollinen keskussairaala
Puheenjohtaja,
Suomalainen mikrobilääkeresistenssin tutkimusryhmä, FiRe
p. 02 313 7451
[email protected]